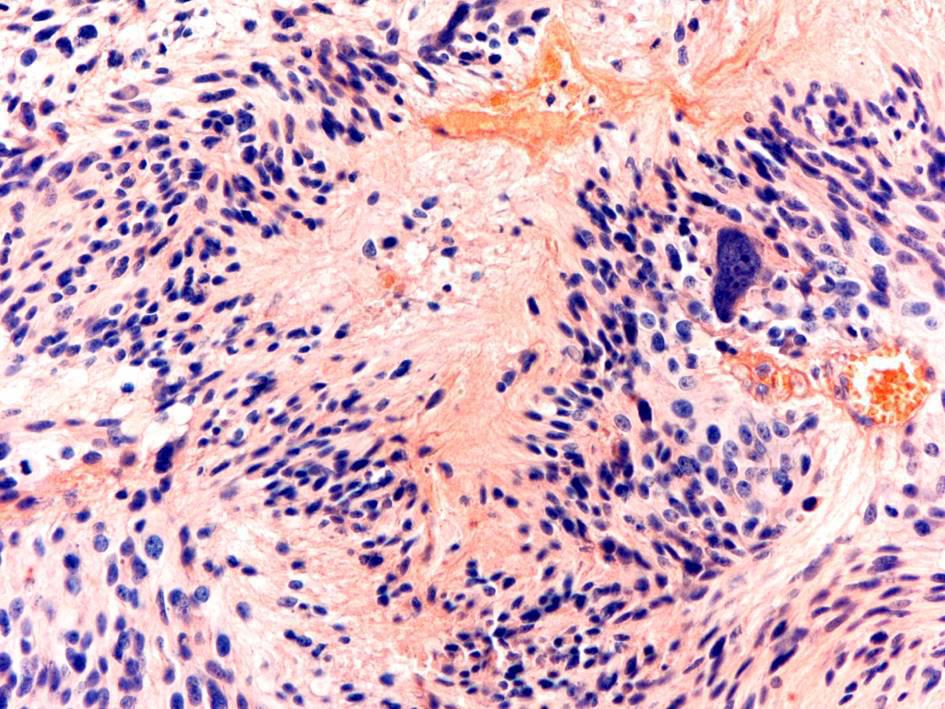
infographic

Wyszukaj egzamin lub pytanie
Egzamin PES Neurologia / jesień 2018
120 pytań
Pytanie 1
Ocena morfologiczna wycinka mięśniowego pozwala na ustalenie rozpoznania w przypadku wszystkich chorób wymienionych poniżej, z wyjątkiem:
Pytanie 2
Objawami różnicującymi stwardnienie boczne zanikowe i wieloogniskową neuropatię ruchową są: 1) obecność objawów rzekomoopuszkowych; 2) obecność zaników mięśni we wczesnym okresie choroby; 3) obecność klonusów; 4) obecność objawów patologicznych z grupy Babińskiego; 5) zanik języka; 6) pozytywna odpowiedź na leczenie IVIg. Prawidłowa odpowiedź to:
Pytanie 3
Wskaż cechę dotyczącą choroby McArdle'a (glikogenoza V, niedobór fosforylazy mięśniowej):
Pytanie 4
Do najczęstszych objawów chorób mitochondrialnych należy:
Pytanie 5
Do cech charakterystycznych miastenii z przeciwciałami przeciwko MuSK należą wszystkie wymienione, z wyjątkiem:
Pytanie 6
Do cech charakterystycznych zespołu miastenicznego Lamberta-Eatona należą:
Pytanie 7
Wskaż cechę, która nie jest charakterystyczna dla dystrofii Emery'ego- Dreifussa (EDMD):
Pytanie 8
U 20-letniego mężczyzny wystąpiło osłabienie i kurcze mięśni dłoni. Na podobne objawy skarży się matka pacjenta. W badaniu elektrofizjologicznym prawdopodobnie można będzie stwierdzić:
Pytanie 9
Hipertermię złośliwą charakteryzuje/ą:
Pytanie 10
Wskaż prawdziwe stwierdzenia dotyczące sporadycznego wtrętowego zapalenia mięśni (sporadic inclusion body myositis - sIBM): 1) występuje w wieku młodzieńczym; 2) występuje najczęściej po 50. r.ż.; 3) częściej chorują kobiety; 4) aktywność CK może być prawidłowa; 5) często występuje razem z innymi chorobami na tle immunologicznym; 6) jest oporne na leczenie kortykosteroidami. Prawidłowa odpowiedź to:
Pytanie 11
W napadzie migreny nie występują:
Pytanie 12
W klasterowym bólu głowy nie występuje:
Pytanie 13
Zespół paranowotworowy Lamberta-Eatona może współistnieć z:
Pytanie 14
W neuralgii trójdzielnej nie występuje/ą:
Pytanie 15
Jak dziedziczy się nerwiakowłókniakowatość typu I?
Pytanie 16
W przypadku którego zaburzenia ustalono jego związek z procesem nowotworowym?
Pytanie 17
Do objawów oponiaka kąta mostowo-móżdżkowego należy:
Pytanie 18
Oponiaki sierpa mózgu okolicy przedruchowej charakteryzuje/ą:
Pytanie 19
Typową lokalizacją struniaka jest:
Pytanie 20
Najczęściej występującym guzem rdzenia kręgowego jest:
Pytanie 21
Wskaż fałszywe stwierdzenie dotyczące stanu padaczkowego:
Pytanie 22
Do leków przeciwpadaczkowych mogących nasilać napady nieświadomości nie należy:
Pytanie 23
Wskaż fałszywe stwierdzenie dotyczące padaczki:
Pytanie 24
Jaka jest szansa urodzenia zdrowego dziecka przez kobietę chorą na padaczkę?
Pytanie 25
Wskaż fałszywe stwierdzenie dotyczące chorych na padaczkę z depresją:
Pytanie 26
Wskaż fałszywe stwierdzenie dotyczące padaczki w wieku podeszłym:
Pytanie 27
Wskaż fałszywe stwierdzenie dotyczące napadów gorączkowych złożonych:
Pytanie 28
Wskaż fałszywe stwierdzenie dotyczące drgawek gorączkowych:
Pytanie 29
Wskaż fałszywe stwierdzenie dotyczące ciąży u chorej na padaczkę:
Pytanie 30
Wskaż fałszywe stwierdzenie dotyczące padaczki:
Pytanie 31
Zespół Devica, choroba zapalna nerwu wzrokowego i rdzenia kręgowego, jest rzadką chorobą autoimmunologiczną. We wczesnych stadiach przypomina stwardnienie rozsiane (SM). Istotną cechą odróżniającą niektórych pacjentów z zespołem Devica, od pacjentów z stwardnieniem rozsianym jest:
Pytanie 32
W nowej klasyfikacji WHO guzów ośrodkowego układu nerwowego z 2016 roku, w diagnostyce glejaków mózgu należy uwzględnić następujące właściwości guza, z wyjątkiem:
Pytanie 33
W badaniu neuropatologicznym mózgu w chorobie Wilsona (zwyrodnienie wątrobowo-soczewkowe) opisywane są charakterystyczne komórki nazywane komórkami Alzheimera typu I. Są one patologiczną formą:
Pytanie 34
W oponiaku anaplastycznym (anaplastic meningioma) III stopień wg WHO, o złośliwości guza decydują następujące cechy, z wyjątkiem:
Pytanie 35
W której strukturze mózgu znajduje się widoczne na rycinie ognisko krwotoczne?

Pytanie 36
W chorobie Alzheimera w badaniu neuropatologicznym mózgu, obserwuje się gromadzenie beta amyloidu w licznych blaszkach starczych, znajdujących się w neuropilu. Poza tym u ponad 80% chorych na chorobę Alzheimera beta amyloid występuje także w:
Pytanie 37
W mózgach osób z wirusowym zapaleniem mózgu, spowodowanym wirusem wścieklizny, zakażone neurony zawierają diagnostyczne okrągłe lub owalne cytoplazmatyczne wtręty eozynochłonne, będące nagromadzenia wirusa, nazywane:
Pytanie 38
U pacjentki z incydentami niedokrwiennymi lub krwotokami, ze stwierdzonym zwężeniem, wrodzoną hipoplazją lub niedrożnością końcowego odcinka tętnic szyjnych wewnętrznych, można podejrzewać:
Pytanie 39
Obszar wokół ogniska zawału mózgu, objęty procesem niedokrwiennym, ale mogący ulec procesowi naprawczemu, gdy w badaniach za pomocą PET udokumentowano w tym obszarze mały mózgowy przepływ krwi, względnie dobrze zachowany mózgowy metabolizm tlenu nazywa się:
Pytanie 40
Olbrzymia owalna/okrągła komórka pochodzenia astroglejowego, o wymiarach do 90 μm z pojedynczym na ogół jądrem położonym na obwodzie ziarnistej (rzadziej homogennej) obfitej cytoplazmy, opisywana jest w mózgach chorych na chorobę Wilsona, a nazwana komórką Opalskiego na cześć polskiego lekarza, który opisał jej wygląd morfologiczny. Komórka ta gromadzi w cytoplazmie złogi mukopolisacharydów oraz złogi:
Pytanie 41
Nerw zasłonowy: 1) jest nerwem powstającym z gałęzi brzusznych L2-L4; 2) jest nerwem mieszanym; 3) oddaje gałęzie do stawu biodrowego i kolanowego; 4) czuciowo unerwia skórę dolnej 1/3 części powierzchni przyśrodkowej uda; 5) ruchowo unerwia mięśnie: zasłaniacz wewnętrzny, nadgrzebieniowy, smukły oraz przywodziciele uda. Prawidłowa odpowiedź to:
Pytanie 42
Objawem porażenia nerwu piszczelowego jest:
Pytanie 43
Wskaż fałszywe stwierdzenie dotyczące zespołu grzbietowo-bocznego rdzenia przedłużonego:
Pytanie 44
W zespole jądra czerwiennego: 1) uszkodzenie powstaje w wyniku patologii w dorzeczu międzykonarowych gałęzi przeszywających szczytu tętnicy podstawnej lub bliższego odcinka tętnicy tylnej mózgu; 2) występują objawy uszkodzenia jądra nerwu okoruchowego; 3) stwierdza się drżenie, atetozę i ruchy pląsawicze w wyniku uszkodzenia jądra czerwiennego; 4) występują objawy zespołu móżdżkowego; 5) stwierdza się zaburzenia czucia dotyku, ułożenia i wibracji oraz różnicowania bodźców. Prawidłowa odpowiedź to:
Pytanie 45
Wskaż prawdziwe stwierdzenie dotyczące rzekomego objawu Argylla Robertsona:
Pytanie 46
W zwężeniu początkowego odcinka tętnicy podobojczykowej: 1) stwierdza się istotne różnice w wartości ciśnienia skurczowego mierzone na obu kończynach górnych tzn. wyższe ciśnienie stwierdzane po stronie zwężenia; 2) w II stopniu podkradania tętnicy podobojczykowej w tętnicy kręgowej tożstronnej do zwężenia w fazie skurczowej krew płynie do ręki, w rozkurczu do mózgu; 3) przeciwskazaniem do operacji chirurgicznej jest zespół podkradania III stopnia; 4) wśród objawów mogą wystąpić zawroty głowy, osłabienie w czasie wysiłku kończyny górnej po przeciwnej stronie do zwężenia; 5) u osób młodych należy brać pod uwagę chorobę Takayasu jako przyczynę zwężenia. Prawidłowa odpowiedź to:
Pytanie 47
Wskaż fałszywe stwierdzenie dotyczące badania elektro- i video- nystagmograficznego (ENG/VNG):
Pytanie 48
Wskaż fałszywe stwierdzenie dotyczące zespołu MELAS:
Pytanie 49
Podwyższone stężenie homocysteiny: 1) występuje w heterogennej grupie chorób m.in. w: homocystynurii , zespole Marfana, zespole Weilla-Marchesaniego; 2) jest czynnikiem zwiększającym ryzyko zakrzepicy i zatorowości oraz rozwoju miażdżycy; 3) jest wynikiem zaburzeń przemiany aminokwasu siarkowego - metioniny; 4) koreluje z niedoborem witaminy B6, B12 i kwasu foliowego; 5) może być spowodowana defektem genów dla: syntazy cystationiny, reduktazy metylenotetrahydrofolianu, transkobalaminy. Prawidłowa odpowiedź to:
Pytanie 50
Wskaż prawdziwe stwierdzenia dotyczące miastenii: 1) u około 10% chorych wykrywa się przeciwciała przeciwko MuSK; 2) początek objawów jest najczęstszy między drugą a czwartą dekadą życia; 3) u pacjentów stwierdza się nadmierną męczliwość; 4) w leczeniu stosuje się tymektomię; 5) przełom miasteniczny stwierdza się u około 10% pacjentów z miastenią. Prawidłowa odpowiedź to:
Pytanie 51
Który z poniżej podanych leków stosowanych w SM jest kardiotoksyczny?
Pytanie 52
Wskaż fałszywe stwierdzenia dotyczące zespołu Lamberta-Eatona: 1) występowanie w chorobie przeciwciał przeciwko kanałom wapniowym u 10% pacjentów wiąże się z obecnością raka drobnokomórkowego płuc; 2) występuje osłabienie ksobnych grup mięśni oraz arefleksja w kończynach dolnych; 3) w badaniu EMG obserwuje się obniżenie amplitudy odpowiedzi mięśniowej; 4) objawy autonomiczne występują częściej niż w miastenii; 5) w leczeniu zastosowanie ma plazmafereza. Prawidłowa odpowiedź to:
Pytanie 53
Wskaż prawdziwe stwierdzenia dotyczące stwardnienia rozsianego: 1) odosobniony zespół kliniczny (CIS) zwiastuje początek SM u około 30% chorych; 2) u około 70% chorych występuje spastyczność, najczęściej kończyn dolnych; 3) częstość rzutów w czasie ciąży chorej z SM ulega wyraźnemu zmniejszeniu; 4) u 10% chorych przebieg choroby jest pierwotnie postępujący; 5) u 70-85% chorych wskaźnik IgG jest zwiększony. Prawidłowa odpowiedź to:
Pytanie 54
Wskaż fałszywe stwierdzenia dotyczące zespołu Guillaina-Barrėgo: 1) objawy często są poprzedzane infekcją wirusową układu oddechowego lub pokarmowego; 2) kobiety chorują kilkakrotnie częściej niż mężczyźni; 3) w przebiegu choroby może wystąpić obustronny niedowład mięśni twarzy; 4) liczba komórek w płynie mózgowo-rdzeniowym jest zwykle prawidłowa; 5) glikokortykosteroidy skracają czas trwania choroby i wpływają na polepszenie rokowania. Prawidłowa odpowiedź to:
Pytanie 55
Wskaż prawdziwe stwierdzenia dotyczące wieloogniskowej neuropatii ruchowej: 1) w chorobie występują zaniki mięśni i fascykulacje; 2) objawy są zwykle bardziej nasilone w kończynach górnych; 3) w badaniu emg może wystąpić blok przewodzenia; 4) w leczeniu stosuje się dożylne immunoglobuliny; 5) w surowicy krwi u części chorych obserwuje się przeciwciała anty-GM1. Prawidłowa odpowiedź to:
Pytanie 56
Wśród następujących czynników wymień te, które są niekorzystne rokowniczo w SM: 1) zajęcie móżdżku jako pierwszy objaw; 2) krótki odstęp między pierwszymi dwoma rzutami; 3) młody wiek w momencie zachorowania; 4) zapalenie nerwu wzrokowego jako pierwszy objaw choroby; 5) płeć żeńska. Prawidłowa odpowiedź to:
Pytanie 57
Wskaż fałszywe stwierdzenie dotyczące zapalenia rdzenia kręgowego i nerwów wzrokowych (NMO): 1) mężczyźni chorują częściej niż kobiety; 2) u 10-15% chorych występują objawy uszkodzenia innych struktur iż nerwy wzrokowe i rdzeń kręgowy; 3) niestwierdzenie przeciwciał przeciwko akwaporynie wyklucza rozpozna- nie choroby; 4) obserwuje się ogniska w rdzeniu kręgowym rozciągające się co najmniej na długość trzech segmentów rdzenia; 5) w leczeniu zastosowanie mają steroidy. Prawidłowa odpowiedź to:
Pytanie 58
Wskaż prawdziwe stwierdzenia dotyczące choroby Meniere'a: 1) występują napadowe zawroty głowy; 2) występuje utrata słuchu; 3) występuje szum w uchu; 4) mogą występować nudności i wymioty; 5) w leczeniu stosuje się dietę niskosodową i leki diuretyczne. Prawidłowa odpowiedź to:
Pytanie 59
Przyczyną zaburzonego rytmu okołodobowego może być:
Pytanie 60
Do objawów zespołu Kleinego-Levina nie należy/ą:
Pytanie 61
Choroba Weila jest szczególnie ciężką postacią choroby wywoływanej przez:
Pytanie 62
Schorzeniem, w przebiegu którego nie występuje dysfagia neurogenna jest:
Pytanie 63
Metoda spektroskopii w bliskiej podczerwieni (NIRS, near infrared spectroscopy) znalazła zastosowanie w:
Pytanie 64
Strukturami niewrażliwymi na ból są:
Pytanie 65
Do częstych chłoniaków o pierwotnej lokalizacji w OUN nie należy:
Pytanie 66
Postacią zespołu Guillaina-Barrego nie jest:
Pytanie 67
Do tauopatii należą:
Pytanie 68
Wskaż fałszywe stwierdzenie dotyczące pacjentów z zapaleniem wsierdzia:
Pytanie 69
Do objawów zespołu tętnicy przedniej mózgu nie należy/ą:
Pytanie 70
Porażenie nerwu III po stronie ogniska zawałowego mózgu oraz niedowład połowiczy po stronie przeciwnej to zespół:
Pytanie 71
Skala ABCD2 służy do oceny:
Pytanie 72
Do tzw. wczesnych zmian niedokrwiennych w TK głowy w ostrej fazie udaru mózgu nie należy:
Pytanie 73
Wskaż objawy zespołu tętnicy rdzeniowej przedniej:
Pytanie 74
Wskaż najbardziej prawdopodobne rozpoznanie u pacjenta z następujący- mi objawami: szum stwierdzany osłuchowo, wytrzeszcz gałki ocznej, przekrwienie spojówki, ból pozagałkowy z bólem głowy, oftalmoplegia, zaburzenia widzenia:
Pytanie 75
Wskaż najczęstszą lokalizację tętniaków wewnątrzczaszkowych:
Pytanie 76
Spośród poniższych, wskaż najrzadszy objaw zespołu odwracalnej tylnej encefalopatii (PRES):
Pytanie 77
Leczenie memantyną jest w Polsce rekomendowane w:
Pytanie 78
W której z chorób przebiegających z otępieniem rekomendowane jest leczenie inhibitorami acetylocholinesterazy?
Pytanie 79
Polimorfizm apoliproteiny E ma znaczenie przesądzające o rozpoznaniu:
Pytanie 80
Do stadiów choroby Alzheimera wg NIA-AA należy/ą:
Pytanie 81
Nietrzymanie moczu jako pierwszy objaw w otępieniu jest typowe dla:
Pytanie 82
Jakie znaczenie ma ocena neuropsychologiczna w rozpoznawaniu otępienia?
Pytanie 83
Które z poniższych badań należy do grupy znaczników biologicznych otępienia naczyniopochodnego?
Pytanie 84
Mutacje w genach dla białka tau, progranuliny i C9orf 72 są związane z:
Pytanie 85
Która z wymienionych chorób przebiegających z otępieniem należy do α-synukleinopatii?
Pytanie 86
Ciała Lewy'ego są jednym z najważniejszych markerów neuropatologicz- nych w jednej z najczęstszych chorób neurozwyrodnieniowych. W ich składzie znajduje się:
Pytanie 87
Badanie SPECT z użyciem znacznika DaTSCAN pozwala odróżnić chorobę Parkinsona oraz otępienie z ciałami Lewy'ego od innych wymienionych chorób, z wyjątkiem:
Pytanie 88
Nasilona hipotonia ortostatyczna, występująca od pierwszych lat choroby jest najbardziej typowa dla:
Pytanie 89
W leczeniu pląsawicy w przebiegu choroby Huntingtona lekiem, który może wywołać lub nasilić depresję jest:
Pytanie 90
Do czynników ryzyka rozwoju tzw. późnych dyskinez polekowych nie należy:
Pytanie 91
Wskaż fałszywe stwierdzenie dotyczące połowiczego kurczu twarzy:
Pytanie 92
Dystonie charakteryzują mimowolne skurcze wybranych grup mięśnio- wych, powodujące charakterystyczne ułożenia części ciała (dystonie ogniskowe, segmentalne) lub całego ciała (dystonie uogólnione). Które z wymienionych poniżej schorzeń nie jest przykładem dystonii?
Pytanie 93
Wskaż prawdziwe stwierdzenie dotyczące zasad leczenia w wybranych zaburzeniach ruchowych:
Pytanie 94
W leczeniu krwotoków śródmózgowych stosuje się rutynowo u wszystkich pacjentów: 1) czynnik rFVIIa; 2) leczenie operacyjne; 3) steroidy; 4) mannitol i furosemid; 5) hospitalizację w oddziale udarowym. Prawidłowa odpowiedź to:
Pytanie 95
W przypadku wystąpienia napadu padaczkowego u pacjenta ze 'świeżym' udarem niedokrwiennym mózgu prawdą jest, że: 1) pojedynczy napad nie wymaga następowego leczenia p/padaczkowego; 2) bezwzględnym wskazaniem do dalszego leczenia p/padaczkowego jest stan padaczkowy i napady gromadne; 3) padaczka poudarowa rozwija się u 30-50% pacjentów z udarem; 4) wskazane jest włączenie profilaktyczne leków przeciwpadaczkowych w ostrej fazie udaru; 5) wczesne napady w EEG mogą mieć obraz tzw. FIRDA. Prawidłowa odpowiedź to:
Pytanie 96
Wskaż prawdziwe stwierdzenia dotyczące badania metodą rezonansu magnetycznego mózgu u pacjenta z udarem niedokrwiennym mózgu: 1) w okresie 0-6 godzin od zachorowania obraz w sekwencji T1 wykazuje 'świeże' niedokrwienie mózgu jako obszar hiperintensywny; 2) w okresie 0-6 godzin od zachorowania obraz w sekwencji T2 zwykle nie wykazuje zmian; 3) opcja SWI jest sekwencją najszybciej wykazującą 'świeże' niedokrwienie mózgu; 4) 'świeże' ognisko niedokrwienne mózgu w okresie 0-6 godzin od zacho- rowania ma obraz hiperintensywny w sekwencji DWI i hipointensywny w ADC; 5) MRI w sekwencji T2 w okresie 0-6 godzin od zachorowania lepiej niż TK obrazuje wtórne ukrwotocznienie. Prawidłowa odpowiedź to:
Pytanie 97
W profilaktyce nawrotów udaru niedokrwiennego można stosować przewlekle łącznie następujące leki przeciwpłytkowe: 1) klopidogrel; 2) indobufen; 3) tikagrelol; 4) dipirydamol; 5) aspirynę. Prawidłowa odpowiedź to:
Pytanie 98
W przypadku pacjenta z wysokim ciśnieniem tętniczym > 220/110 mmHg z udarem niedokrwiennym mózgu, u którego planowane jest leczenie trombolityczne r-TPA prawdą jest, że: 1) nie należy obniżać ciśnienia tętniczego; 2) lekami z wyboru są leki moczopędne dożylne lub nitrogliceryna; 3) można zastosować labetalol 200 mg i.v jednorazowo z następczym wlewem infuzyjnym 50 mg/min; 4) w przypadku braku możliwości obniżenia ciśnienia tętniczego poniżej 185/110 mmHg należy odstąpić od leczenia r-TPA; 5) można zastosować urapidyl 10-50 mg i.v. w bolusie. Prawidłowa odpowiedź to:
Pytanie 99
W przypadku zespołu naprzemiennego Claude'a: 1) uszkodzenie zlokalizowane jest w śródmózgowiu, jądrze czerwiennym; 2) po stronie ogniska występuje porażenie n. III; 3) po stronie przeciwnej do ogniska występuje porażenie n. IV, VI i VII; 4) po stronie przeciwnej do ogniska występują niedowład i hemiataksja; 5) po stronie przeciwnej do ogniska występują tylko zburzenia czucia powierzchownego i głębokiego. Prawidłowa odpowiedź to:
Pytanie 100
Skala NIHSS to: 1) skala niepełnosprawności; 2) skala codziennego funkcjonowania; 3) skala opisująca lokalizację udaru; 4) National Institutes of Health Stroke Scale; 5) ocenia punktów ciężkość deficytu neurologicznego u chorych z udarem. Prawidłowa odpowiedź to:
Pytanie 101
Wskaż prawdziwe stwierdzenia dotyczące udaru żylnego OUN: 1) głównym czynnikiem ryzyka jest nadciśnienie tętnicze; 2) chorują głownie mężczyźni w wieku starszym; 3) choroba nowotworowa nie zwiększa ryzyka; 4) hormonalne środki antykoncepcyjne zwiększa ryzyko; 5) odwodnienie zwiększa ryzyko choroby. Prawidłowa odpowiedź to:
Pytanie 102
Bezwzględnymi przeciwwskazaniami do leczenia trombolitycznego udaru niedokrwiennego mózgu są: 1) wiek powyżej 80 lat; 2) czas od wystąpienia udaru do przybycia do szpitala powyżej 6 godz.; 3) jakakolwiek świeża zmiana krwotoczna wewnątrzczaszkowa w badaniu TK głowy; 4) brak potwierdzenia niedokrwienia mózgu badaniem TK głowy; 5) udar u kobiety w wieku rozrodczym. Prawidłowa odpowiedź to:
Pytanie 103
Zespół Meige'a typu II: 1) klasyfikuje się do dystonii segmentarnych; 2) klasyfikuje się do dystonii wieloogniskowych; 3) charakteryzuje się kurczem powiek z towarzyszącą dystonią szyjno- twarzową; 4) charakteryzuje się kurczem powiek z towarzyszącą dystonią ustno- żuchwową. Prawidłowa odpowiedź to:
Pytanie 104
Wskaż prawdziwe stwierdzenia dotyczące zespołu niespokojnych nóg: 1) jest to przymus poruszania kończynami dolnymi bardziej nasilony wieczorem i w nocy; 2) kofeina i napoje energetyzujące nie wpływają na objawy zespołu niespokojnych nóg; 3) w terapii zespołu niespokojnych nóg wykorzystuje się leki dopaminergiczne, opioidy, leki przeciwpadaczkowe; 4) poprawa po próbnej terapii lekami dopaminergicznymi potwierdza rozpoznanie. Prawidłowa odpowiedź to:
Pytanie 105
Które z poniższych objawów mogą wskazywać na uszkodzenie górnego motoneuronu? 1) wzmożone napięcie mięśni; 2) wiotkie napięcie mięśni; 3) osłabienie odruchów ścięgnistych; 4) wygórowanie odruchów ścięgnistych; 5) dodatni objaw Babińskiego. Prawidłowa odpowiedź to:
Pytanie 106
Mężczyzna 48-letni zgłosił się do Izby Przyjęć z powodu piorunującego, bardzo silnego bólu głowy (9/10 w skali VAS). Objawy pojawiły się w sposób nagły, po defekacji, ból lokalizował się głównie w okolicy potylicznej. Ponadto chory podawał nudności i zawroty oraz niestabilność przy chodzeniu. W badaniu neurologicznym stwierdzono niewielką sztywność karku, oczopląs poziomy zmiennokierunkowy. Jakie jest najbardziej prawdopodobne rozpoznanie?
Pytanie 107
Do wczesnych powikłań zapalenia opon mózgowo-rdzeniowych należą: 1) wodogłowie zapalne; 2) stan padaczkowy; 3) niedowłady lub porażenia spastyczne; 4) uszkodzenie nerwów czaszkowych; 5) udary. Prawidłowa odpowiedź to:
Pytanie 108
Cechą otępienia naczyniopochodnego nie jest: 1) niewielki w porównaniu z chorobą Alzheimera deficyt pamięci epizodycznej; 2) wczesne osłabienie uwagi; 3) wczesne występowanie zaburzeń wykonawczych; 4) wczesne zaburzenia zachowania i zmiany osobowości; 5) wczesne zaburzenia językowe. Prawidłowa odpowiedź to:
Pytanie 109
10-letnia dziewczynka została skierowana do szpitala z powodu krótko- trwałych zaburzeń świadomości. Objawy występowały wielokrotnie w ciągu dnia, trwały zwykle kilka sekund i polegały na przerywaniu odbywanej czynności. W badaniu EEG z nieprawidłowości stwierdzono rytmiczne zespoły iglica-fala wolna o częstotliwości 3Hz. Jaki lek można zastosować w początkowej monoterapii? 1) karbamazepinę; 2) fenytoinę; 3) lakozamid; 4) etosuksymid; 5) kwas walproinowy. Prawidłowa odpowiedź to:
Pytanie 110
Lekami stosunkowo bezpiecznymi w ciąży, lecz wymagającymi modyfi- kacji dawki z powodu istotnego zwiększenia ich klirensu w ostatnim trymestrze ciąży są: 1) kwas walproinowy; 2) lewetyracetam; 3) lamotrygina; 4) fenytoina; 5) etosuksymid. Prawidłowa odpowiedź to:
Pytanie 111
Do leków przeciwpadaczkowych, które indukują enzymy mikrosomalne wątroby i mogą obniżać stężenie leków przeciwzakrzepowych (np. warfaryny), nie należą: 1) fenytoina; 2) lewetyracetam; 3) karbamazepina; 4) gabapentyna; 5) kwas walproinowy; 6) topiramat. Prawidłowa odpowiedź to:
Pytanie 112
W przypadku chorych z ataksją genetycznie uwarunkowaną szczególną czujność onkologiczną należy zachować u chorych z:
Pytanie 113
W odniesieniu do ataksji Friedreicha nieprawdą jest, że:
Pytanie 114
Najskuteczniejsze w leczeniu drżenia samoistnego są:
Pytanie 115
60-letni mężczyzna zgłosił się z powodu postępującego od ok. roku pogorszenia sprawności ruchowej - jest znacznie wolniejszy w wykonywaniu czynności dnia codziennego, wolniej chodzi, parokrotnie przewrócił się, skarży się też na pogorszenie ostrości widzenia, ma problemy z wyraźnym mówieniem. W badaniu fizykalnym: spowolnienie psychoruchowe, hipomimia, dyzartria, zaburze- nia skojarzonych ruchów gałek ocznych w pionie - głównie ku dołowi, sztywność dominująca w mięśniach osiowych, bradykinezja kończyn. Wskaż najbardziej prawdopodobne rozpoznanie:
Pytanie 116
67-letnia praworęczna kobieta lecząca się z powodu choroby Gravesa- Basedowa zgłosiła się z powodu występującego od kilku miesięcy drżenia prawej dłoni, szczególnie nasilającego się pod wpływem emocji. W badaniu fizykalnym: dyskretna hipomimia, drżenie spoczynkowe prawej dłoni, niewielka sztywność i bradykinezja prawych kończyn, ograniczenie współruchów prawej kończyny górnej podczas chodzenia. Najbardziej prawdopodobnym podejrzeniem jest:
Pytanie 117
Dystonia, jako część obrazu klinicznego, występuje w szeregu chorób neurozwyrodnieniowych, z wyjątkiem:
Pytanie 118
W procesie diagnostycznym ataksji o wczesnym początku najmniej przydatne jest oznaczenie:
Pytanie 119
W leukodystrofii metachromatycznej:
Pytanie 120



